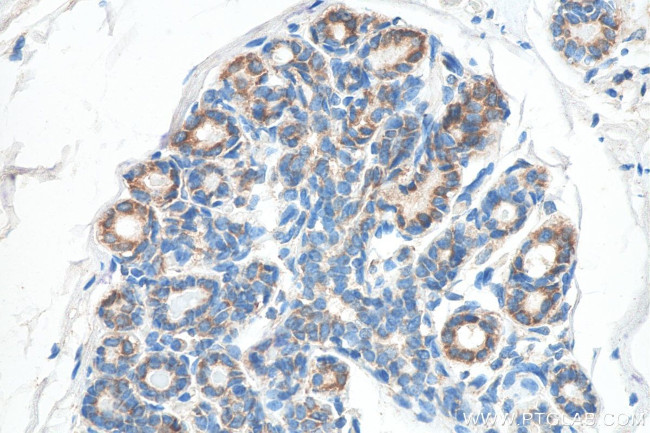
CXCR4 Antibody in Immunohistochemistry (Paraffin) (IHC (P))

Search
Proteintech
CXCR4 Monoclonal Antibody (4B5E4), Biotin
{{$productOrderCtrl.translations['antibody.pdp.commerceCard.promotion.promotions']}}
{{$productOrderCtrl.translations['antibody.pdp.commerceCard.promotion.viewpromo']}}
{{$productOrderCtrl.translations['antibody.pdp.commerceCard.promotion.promocode']}}: {{promo.promoCode}} {{promo.promoTitle}} {{promo.promoDescription}}. {{$productOrderCtrl.translations['antibody.pdp.commerceCard.promotion.learnmore']}}






Please note: We are reviewing Western blot images included in the antibody testing data in our catalog, including those provided by third parties. Unless expressly labeled or annotated as “raw-unedited”, Western blot images included in the antibody testing data in our catalog may have been edited, optimized or otherwise adjusted for presentation.
产品信息
BIOTN60042100UL
种属反应
宿主/亚型
分类
类型
克隆号
偶联物
形式
浓度
规格
纯化类型
保存液
内含物
保存条件
运输条件
靶标信息
CXCR4 (Fusin, LESTR, HUMSTR) is a member of the G-protein-coupled chemokine receptor family with seven membrane-spanning domains, and functions as a co-receptor for X4 HIV-1 entry into CD4+ cells. CXCR4 has been proved to be the co-receptor for HIV-2's binding to CD4 through envelope glycoprotein gp 120 and promotes Env-mediated fusion of the virus. In other cases, CXCR4 can even function as the only receptor for HIV-2's binding to the CD4 host cells. CXCR4 is the receptor for the C-X-C chemokine CXCL12/SDF-1 that transduces a signal by increasing intracellular calcium ion levels and enhancing MAPK1/MAPK3 activation. CXCR4 acts as a receptor for extracellular ubiquitin; leading to enhanced intracellular calcium ions and reduced cellular cAMP levels. Also, CXCR4 is involved in hematopoiesis and in cardiac ventricular septum formation, and plays an essential role in vascularization of the gastrointestinal tract, probably by regulating vascular branching and/or remodeling processes in endothelial cells. In the CNS, CXCR4 could mediate hippocampal-neuron survival and is involved in cerebellar development. CXCR4 binds bacterial lipopolysaccharide (LPS) and mediates LPS-induced inflammatory response, including TNF secretion by monocytes. Antibodies to CXCR4 block HIV-1 and HIV-2 fusion and infection of human target cells. The amino-terminal domain and the second extracellular loop of CXCR4 serve as HIV biding sites.
仅用于科研。不用于诊断过程。未经明确授权不得转售。
篇参考文献 (0)
生物信息学
蛋白别名: C Cmotif chemokine; C X C motif chemokine; C-X-C chemokine receptor type 4; CC motif chemokine; CCmotif chemokine; CD antigen CD184; CD184; chemokine (C-X-C) receptor 4; chemokine receptor 4; CXC; CXC motif chemokine; CXC-R4; CXCR-4; FB22; Fusin; HM89; HUMSTR; LAP-3; LCR1; LESTR; Leukocyte-derived seven transmembrane domain receptor; leukocyte-expressed seven-transmembrane-domain; Lipopolysaccharide-associated protein 3; NPYRL; PB-CKR; Pre-B-cell-derived chemokine receptor; SDF-1 receptor; Stromal cell-derived factor 1 receptor
基因别名: b2b220Clo; CD184; Cmkar4; CXCR4; LESTR; PB-CKR; PBSF/SDF-1; Sdf1r
UniProt ID: (Mouse) P70658
Entrez Gene ID: (Mouse) 12767